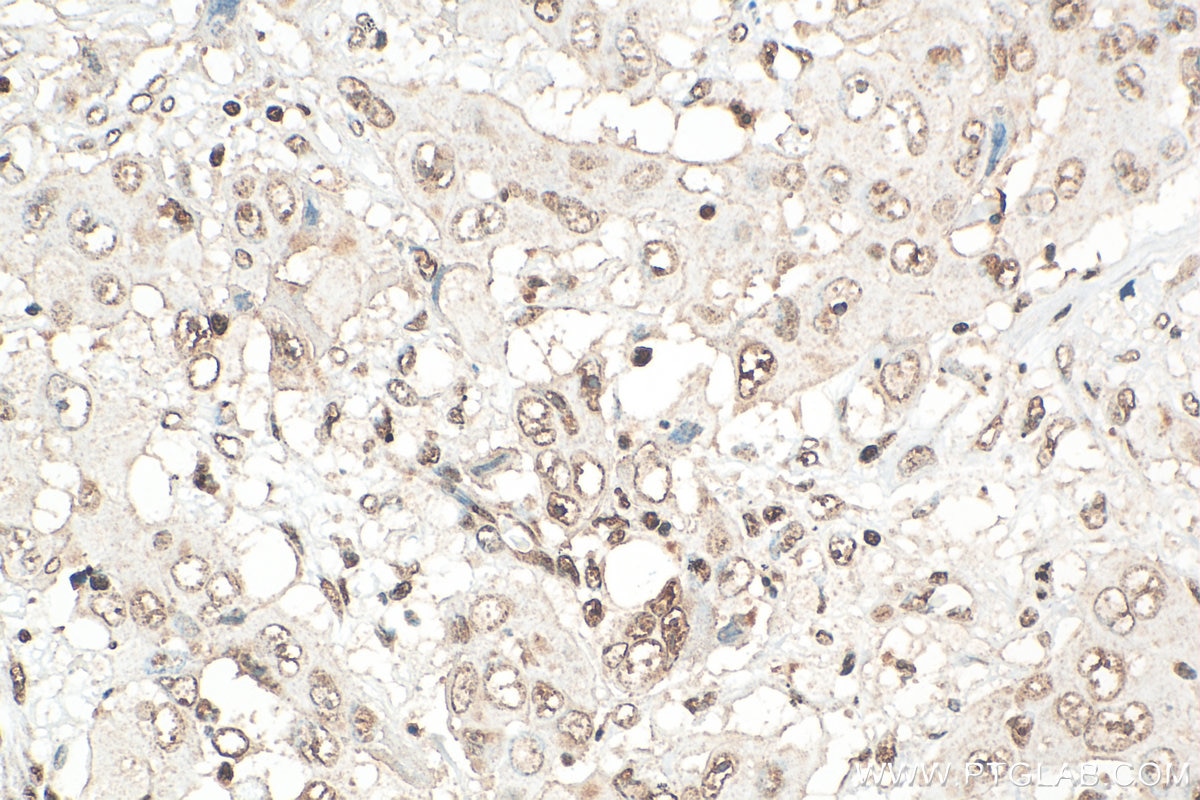
Immunohistochemistry (IHC) staining of human lung cancer tissue using DAPK3 Polyclonal antibody (30656-1-AP)

Tested Applications
| Positive WB detected in | A431 cells, HEK-293 cells, Hela cells, HepG2 cells |
| Positive IHC detected in | human lung cancer tissue Note: suggested antigen retrieval with TE buffer pH 9.0; (*) Alternatively, antigen retrieval may be performed with citrate buffer pH 6.0 |
| Positive IF/ICC detected in | A431 cells |
Recommended dilution
| Application | Dilution |
|---|---|
| Western Blot (WB) | WB : 1:2000-1:12000 |
| Immunohistochemistry (IHC) | IHC : 1:500-1:2000 |
| Immunofluorescence (IF)/ICC | IF/ICC : 1:50-1:500 |
| It is recommended that this reagent should be titrated in each testing system to obtain optimal results. | |
| Sample-dependent, Check data in validation data gallery. | |
Published Applications
| KD/KO | See 2 publications below |
| WB | See 3 publications below |
| IHC | See 1 publications below |
| IF | See 1 publications below |
| CoIP | See 2 publications below |
Product Information
30656-1-AP targets DAPK3 in WB, IHC, IF/ICC, CoIP, ELISA applications and shows reactivity with human samples.
| Tested Reactivity | human |
| Cited Reactivity | human, mouse, rat |
| Host / Isotype | Rabbit / IgG |
| Class | Polyclonal |
| Type | Antibody |
| Immunogen |
CatNo: Ag33051 Product name: Recombinant human DAPK3 protein Source: e coli.-derived, PET28a Tag: 6*His Domain: 252-361 aa of NM_001348 Sequence: IRRLLVKDPKRRMTIAQSLEHSWIKAIRRRNVRGEDSGRKPERRRLKTTRLKEYTIKSHSSLPPNNSYADFERFSKVLEEAAAAEEGLRELQRSRRLCHEDVEALAAIYE Predict reactive species |
| Full Name | death-associated protein kinase 3 |
| Calculated Molecular Weight | 53 kDa |
| Observed Molecular Weight | 37, 52 kDa |
| GenBank Accession Number | NM_001348 |
| Gene Symbol | DAPK3 |
| Gene ID (NCBI) | 1613 |
| RRID | AB_3086381 |
| Conjugate | Unconjugated |
| Form | Liquid |
| Purification Method | Antigen affinity purification |
| UNIPROT ID | O43293 |
| Storage Buffer | PBS with 0.02% sodium azide and 50% glycerol, pH 7.3. |
| Storage Conditions | Store at -20°C. Stable for one year after shipment. Aliquoting is unnecessary for -20oC storage. 20ul sizes contain 0.1% BSA. |
Background Information
DAPK3, also named as ZIPK and Dlk, belongs to the protein kinase superfamily, CAMK Ser/Thr protein kinase family and DAP kinase subfamily. The calculated molecular weight of DAPK3 is 52 kDa. This antibody can recognize the 37 kDa isoform of target. ZIP kinase is a Serine/threonine kinase which acts as a positive regulator of apoptosis. ZIP kinasephosphorylates histone H3 on 'Thr-11' at centromeres during mitosis. ZIP kinase regulates myosin light chain phosphatase through phosphorylation of MYPT1 thereby regulating the assembly of the actin cytoskeleton, cell migration, invasiveness of tumor cells, smooth muscle contraction and neurite outgrowth. It catalyze the reaction: ATP + a protein = ADP + a phosphoprotein.
Protocols
| Product Specific Protocols | |
|---|---|
| IF protocol for DAPK3 antibody 30656-1-AP | Download protocol |
| IHC protocol for DAPK3 antibody 30656-1-AP | Download protocol |
| WB protocol for DAPK3 antibody 30656-1-AP | Download protocol |
| Standard Protocols | |
|---|---|
| Click here to view our Standard Protocols |
Publications
| Species | Application | Title |
|---|---|---|
Biochem Biophys Res Commun Protection of blood-brain barrier by endothelial DAPK1 deletion after stroke | ||
J Hepatol eIF3f promotes tumour malignancy by remodelling fatty acid biosynthesis in hepatocellular carcinoma
| ||
Acta Biochim Biophys Sin (Shanghai) ZIPK collaborates with STAT5A in p53-mediated ROS accumulation in hyperglycemia-induced vascular injury
|